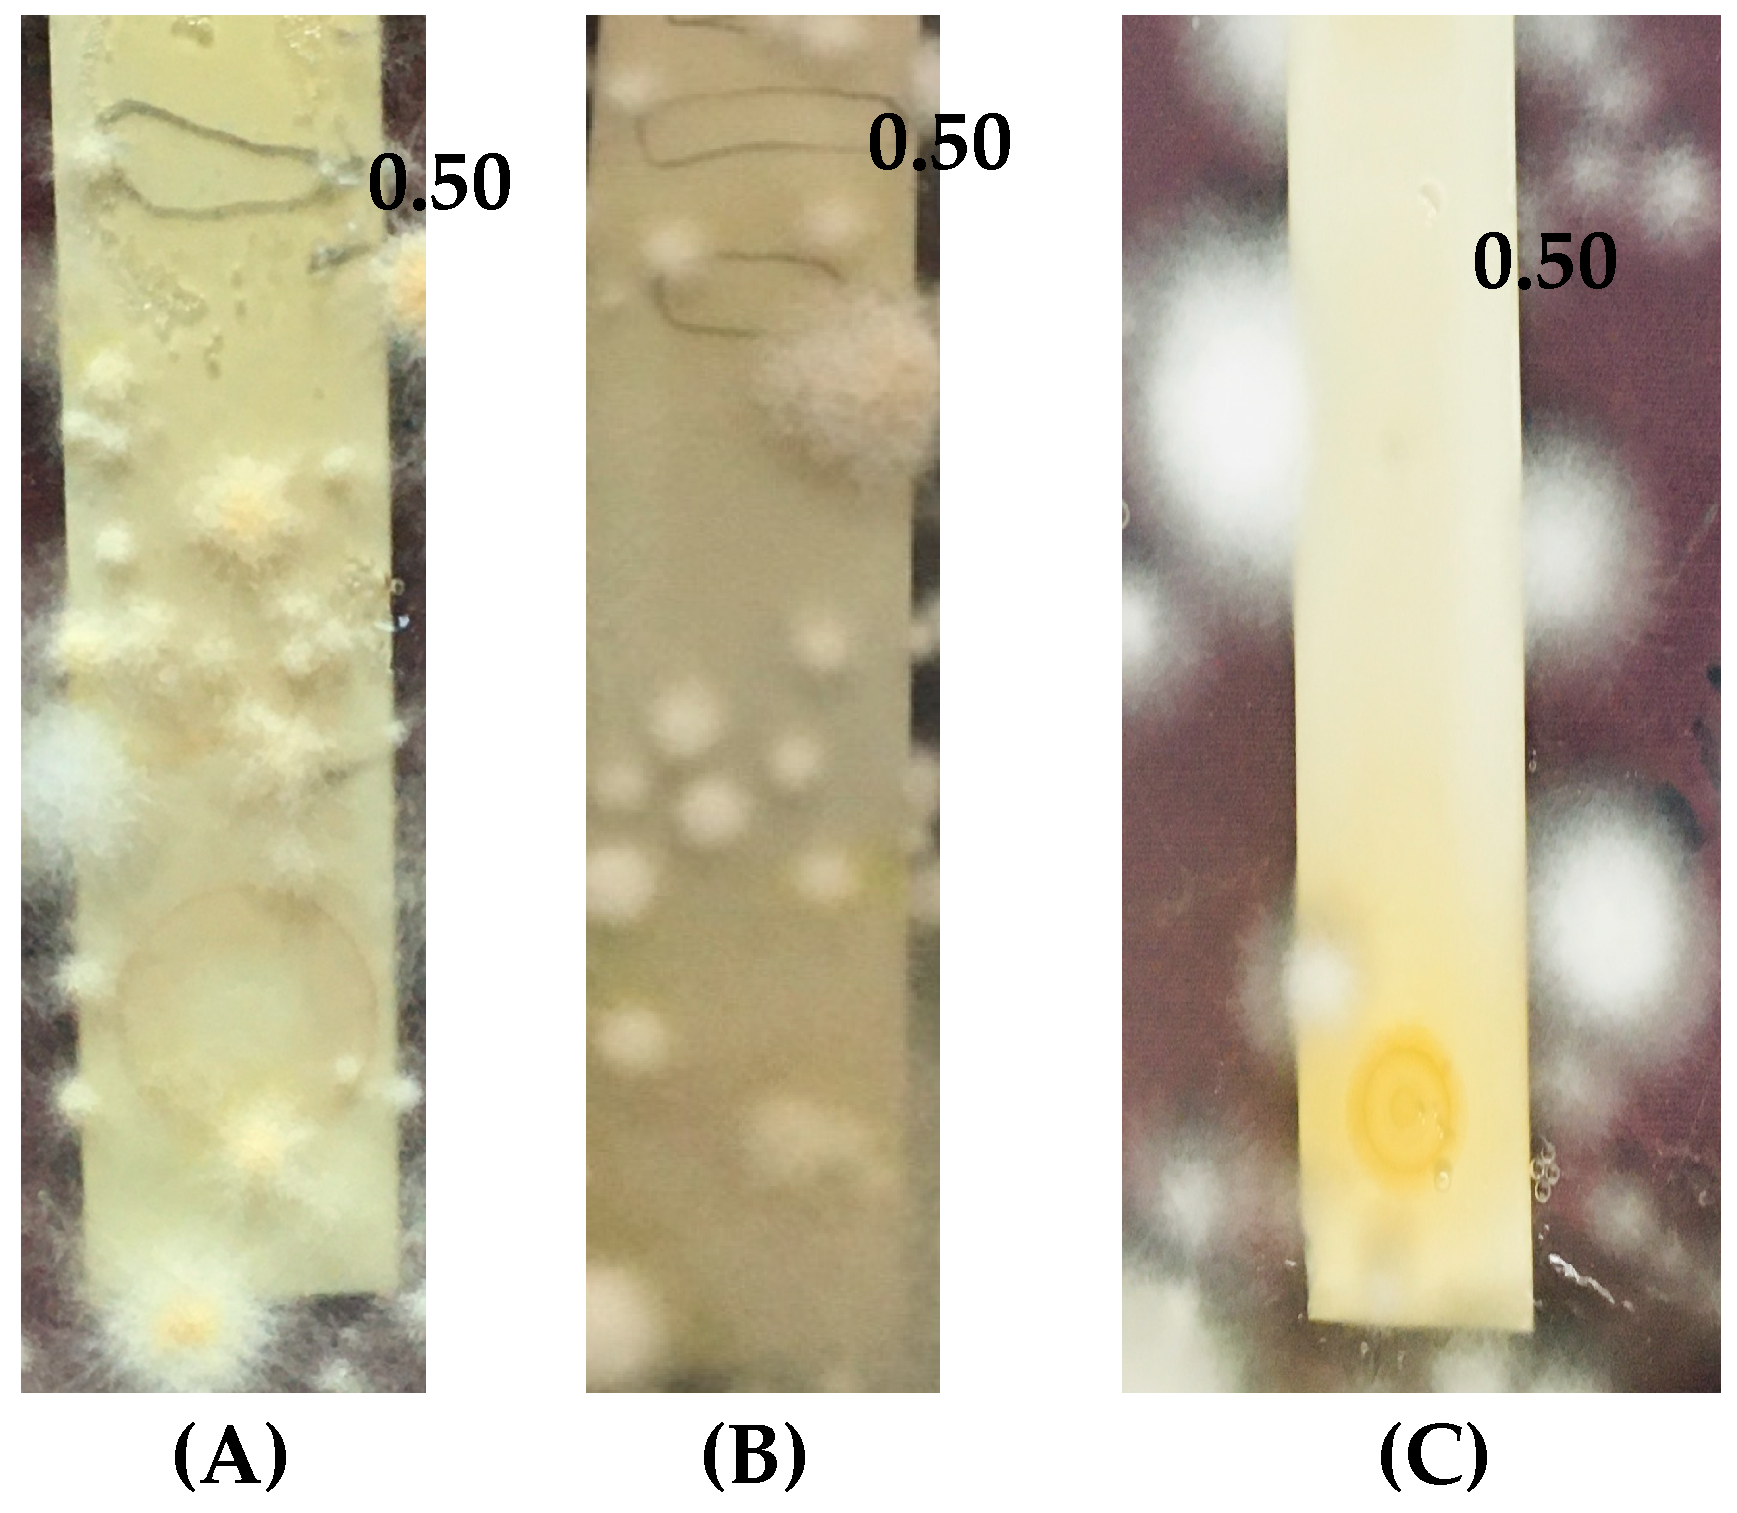
Molecules 30 03595 g002

Bioactivity-Guided Isolation of Flavone Glycoside from Terminalia catappa: Evaluating Anti-MRSA and Anti-Dermatophytic Potential
Abstract
1. Introduction
2. Results
2.1. Column Chromatography and the TLC Profile of Isolated Fractions
2.2. Agar Overlay Bioautography of Eluted Compound from Fraction 2
2.3. Agar Overlay Bioautography of Eluted Compounds from Fraction 2 Against Test Bacteria
2.4. Agar Overlay Bioautography of Eluted Compounds from Fraction 2 Against Dermatophytes
2.5. Isolation of the Antimicrobial Compound by Preparative Thin-Layer Chromatography
2.6. Characterization and Structure Elucidation of the Antimicrobial Compound
2.6.1. HRLCMS Profile of the Antimicrobial Compound
2.6.2. FT-IR Analysis of the Antimicrobial Compound
2.6.3. 1HNMR Analysis of Apigenin 7-O-ß-D-Glucopyranoside
2.7. Efficacy of Apigenin 7-O-ß-D-Glucopyranoside Evaluated by Minimum Inhibitory Concentration and Minimum Bactericidal Concentration
2.7.1. Antibacterial Activity of Apigenin 7-O-ß-D-Glucopyranoside
2.7.2. Antifungal Activity of Apigenin 7-O-ß-D-Glucopyranoside Against Dermatophytes
3. Discussion
4. Materials and Methods
4.1. Chemicals and Microorganisms
4.2. Extraction and Purification
4.3. Detection of Antimicrobial Compounds by the Agar Overlay Bioautography Assay
4.4. Characterization and Structure Elucidation of the Antimicrobial Compound
4.4.1. High-Resolution LCMS Characterization of the Antimicrobial Compound
4.4.2. FT-IR Characterization of the Antimicrobial Compound
4.4.3. 1HNMR Spectral Analysis of the Antimicrobial Compound
4.5. Antimicrobial Efficacy of the Isolated Antimicrobial Compound
5. Conclusions
Author Contributions
Funding
Institutional Review Board Statement
Informed Consent Statement
Data Availability Statement
Acknowledgments
Conflicts of Interest
Abbreviations
| MDR | multidrug resistance |
| MRSA | Methicillin-resistant Staphylococcus aureus |
| CDC | Center for Disease Control and Prevention |
| GLASS | global antimicrobial surveillance system |
| CAGR | compound annual growth rate |
| WHO | World Health Organization |
| TLC | thin-layer chromatography |
| Rt | retention time |
| Rf | retention factor |
| MIC | minimum inhibitory concentration |
| MFC | minimum fungicidal concentration |
| MBC | minimum bactericidal concentration |
| TTC | 2,3,5-Triphenyl tertrazolium chloride |
References
- Abdissa, D.; Geleta, G.; Bacha, K.; Abdissa, N. Phytochemical investigation of Aloe pulcherrima roots and evaluation for its antibacterial and antiplasmodial activities. PLoS ONE 2017, 12, e0173882. [Google Scholar] [CrossRef] [PubMed]
- Demgne, O.M.F.; Damen, F.; Fankam, A.G.; Guefack, M.-G.F.; Wamba, B.E.N.; Nayim, P.; Mbaveng, A.T.; Bitchagno, G.T.M.; Tapondjou, L.A.; Penlap, V.B.; et al. Botanicals and phytochemicals from the bark of Hypericum roeperianum (Hypericaceae) had strong antibacterial activity and showed synergistic effects with antibiotics against multidrug-resistant bacteria expressing active efflux pumps. J. Ethnopharmacol. 2017, 277, 114257. [Google Scholar] [CrossRef] [PubMed]
- Okwu, M.U.; Olley, M.; Akpoka, A.O.; Izevbuwa, O.E. Methicillin-resistant Staphylococcus aureus (MRSA) and anti-MRSA activities of extracts of some medicinal plants: A brief review. AIMS Microbiol. 2019, 5, 117–137. [Google Scholar] [CrossRef] [PubMed]
- Tan, L.; Zhou, Z.; Liu, X.; Li, J.; Zheng, Y.; Cui, Z.; Yang, X.; Liang, Y.; Li, Z.; Feng, X.; et al. Overcoming Multidrug-Resistant MRSA Using Conventional Aminoglycoside Antibiotics. Adv. Sci. 2020, 7, 1902070. [Google Scholar] [CrossRef]
- Pasrija, P.; Girdhar, M.; Kumar, M.; Arora, S.; Katyal, A. Endophytes: An unexplored treasure to combat Multidrug resistance. Phytomed. Plus 2022, 2, 100249. [Google Scholar] [CrossRef]
- Keita, K.; Darkoh, C.; Okafor, F. Secondary plant metabolites as potent drug candidates against antimicrobial-resistant pathogens. SN Appl. Sci. 2022, 4, 209. [Google Scholar] [CrossRef]
- Lockhart, S.R.; Chowdhary, A.; Gold, J.A.W. The rapid emergence of antifungal-resistant human-pathogenic fungi. Nat. Rev. Microbiol. 2023, 21, 818–832. [Google Scholar] [CrossRef]
- Tanwar, J.; Das, S.; Fatima, Z.; Hameed, S. Multi-drug resistance: An emerging crisis. Interdiscip. Perspect. Infect. Dis. 2014, 2014, 541340. [Google Scholar] [CrossRef]
- Revie, N.M.; Iyer, K.R.; Robbins, N.; Cowen, L.E. Antifungal drug resistance: Evolution, mechanisms and impact. Curr. Opin. Microbiol. 2018, 45, 70–76. [Google Scholar] [CrossRef]
- Liang, M.; Ge, X.; Xua, H.; Ma, K.; Zhang, W.; Zan, Y.; Efferth, T.; Xue, Z.; Hua, X. Phytochemicals with activity against Methicillin-resistant Staphylococcus aureus. Phytomedicine 2021, 100, 154073. [Google Scholar] [CrossRef]
- Mattio, L.M.; Dallavalle, S.; Musso, L.; Filardi, R.; Franzetti, L.; Pellegrino, L.; D’Incecco, P.; Mora, D.; Pinto, A.; Arioli, S. Antimicrobial activity of resveratrol-derived monomers and dimers against foodborne pathogens. Sci. Rep. 2019, 9, 19525. [Google Scholar] [CrossRef] [PubMed]
- Suganya, T.; Packiavathy, I.A.S.V.; Aseervatham, G.S.B.; Carmona, A.; Rashmi, V.; Mariappan, S.; Devi, N.R.; Ananth, D.A. Tackling Multiple-Drug-Resistant Bacteria with Conventional and Complex Phytochemicals. Front. Cell. Infect. Microbiol. 2022, 12, 883839. [Google Scholar] [CrossRef]
- Tiwari, P.; Bajpai, M.; Sharma, A. Antimicrobials from Medicinal Plants: Key Examples, Success Stories and Prospects in Tackling Antibiotic Resistance. Lett. Drug Des. Discov. 2023, 20, 420–438. [Google Scholar] [CrossRef]
- Fiamegos, Y.C.; Kastritis, P.L.; Exarchou, V.; Han, H.; Bonvin, A.M.; Vervoort, J.; Tegos, G.P. Antimicrobial and efflux pump inhibitory activity of caffeoylquinic acids from Artemisia absinthium against gram-positive pathogenic bacteria. PLoS ONE 2011, 6, e18127. [Google Scholar] [CrossRef] [PubMed]
- Shin, J.; Prabhakaran, V.S.; Kim, K.S. The multi-faceted potential of plant-derived metabolites as antimicrobial agents against multidrug-resistant pathogens. Microb. Pathog. 2018, 116, 209–214. [Google Scholar] [CrossRef] [PubMed]
- Shriram, V.; Khare, T.; Bhagwat, R.; Shukla, R.; Kumar, V. Inhibiting bacterial drug efflux pumps via phyto-therapeutics to combat threatening antimicrobial resistance. Front. Microbiol. 2018, 9, 2990. [Google Scholar] [CrossRef]
- Mishra, M.P.; Rath, S.; Swain, S.S.; Ghosh, G.; Das, D.; Padhy, R.N. In vitro antibacterial activity of crude extracts of 9 selected medicinal plants against UTI causing MDR bacteria. J. King Saud Univ. Sci. 2017, 29, 84–95. [Google Scholar] [CrossRef]
- Suleiman, M.M.; McGaw, L.I.; Naidoo, V.; Eloff, J. Detection of antimicrobial compounds by bioautography of different extracts of leaves of selected South African tree species. Afr. J. Tradit. Complement. Altern. Med. 2010, 7, 64–78. [Google Scholar] [CrossRef]
- Divya, N.; Rengarajan, R.L.; Radhakrishnan, R.; Fathi Abd_Allah, E.; Alqarawi, A.A.; Hashem, A.; Manikandan, R.; Vijaya Anand, A. Phytotherapeutic efficacy of the medicinal plant Terminalia catappa L. Saudi J. Biol. Sci. 2019, 26, 985–988. [Google Scholar] [CrossRef]
- Enadeghe, R.; Asoya, E.V.; Iluma, J.; Kolawole, O.; Omoregie, A.E. Phytochemistry and Acute Toxicity Study of Aqueous and Methanol Stem Bark Extract of Terminalia catappa. Trop. J. Nat. Prod. Res. 2022, 6, 931–937. [Google Scholar] [CrossRef]
- Ramanan, S.S.; Arunachalam, A.; Singh, R.; Verdiya, A. Tropical almond (Terminalia catappa): A holistic review. Heliyon 2025, 11, e41115. [Google Scholar] [CrossRef] [PubMed]
- Tabansi, D.; Dahiru, D.; Patrick, A.T.; Jahng, W.J. Anti-Atherosclerosis and Anti-Hyperlipidemia Functions of Terminalia catappa Fruit. ACS Omega 2023, 8, 35571–35579. [Google Scholar] [CrossRef] [PubMed]
- Mwangi, W.C.; Waudo, W.; Shigwenya, M.E.; Gichuki, J. Phytochemical characterization, antimicrobial and antioxidant activities of Terminalia catappa methanol and aqueous extracts. BMC Complement. Med. Ther. 2024, 24, 137. [Google Scholar] [CrossRef] [PubMed]
- Iheagwam, F.N.; Iheagwam, O.T.; Onuoha, M.K.; Ogunlana, O.O.; Chinedu, S.N. Terminalia catappa aqueous leaf extract reverses insulin resistance, improves glucose transport and activates PI3K/AKT signalling in high fat/streptozotocin-induced diabetic rats. Sci. Rep. 2022, 12, 10711. [Google Scholar] [CrossRef]
- Huang, Y.H.; Wu, P.Y.; Wen, K.C.; Lin, C.Y.; Chiang, H.M. Protective effects and mechanisms of Terminalia catappa L. methanolic extract on hydrogen-peroxide-induced oxidative stress in human skin fibroblasts. BMC Complement. Altern. Med. 2018, 18, 266. [Google Scholar] [CrossRef]
- Zanatta, A.C.; Vieira, N.C.; Dantas-Medeiros, R.; Vilegas, W.; Edrada-Ebel, R. Understanding the Seasonal Effect of Metabolite Production in Terminalia catappa L. Leaves through a Concatenated MS- and NMR-Based Metabolomics Approach. Metabolites 2023, 13, 349. [Google Scholar] [CrossRef]
- Zhang, X.R.; Kaunda, J.S.; Zhu, H.T.; Wang, D.; Yang, C.R.; Zhang, Y.J. The Genus Terminalia (Combretaceae): An Ethnopharmacological, Phytochemical and Pharmacological Review. Nat. Prod. Bioprospect. 2019, 9, 357–392. [Google Scholar] [CrossRef]
- Terças, A.G.; Monteiro, A.d.S.; Moffa, E.B.; dos Santos, J.R.A.; de Sousa, E.M.; Pinto, A.R.B.; Costa, P.C.d.S.; Borges, A.C.R.; Torres, L.M.B.; Barros Filho, A.K.D.; et al. Phytochemical characterization of Terminalia catappa Linn. extracts and their antifungal activities against Candida spp. Front. Microbiol. 2017, 8, 595. [Google Scholar] [CrossRef]
- Sowmya, T.N.; Raveesha, K.A. Polyphenol-rich purified bioactive fraction isolated from Terminalia catappa L.: UHPLC-MS/MS-based metabolite identification and evaluation of their antimicrobial potential. Coatings 2021, 11, 1210. [Google Scholar] [CrossRef]
- Álvarez-Martínez, F.J.; Barrajón-Catalán, E.; Herranz-López, M.; Micol, V. Antibacterial plant compounds, extracts and essential oils: An updated review on their effects and putative mechanisms of action. Phytomedicine 2021, 90, 153626. [Google Scholar] [CrossRef]
- Aziz, P.; Muhammad, N.; Intisar, A.; Abid, M.A.; Din, M.I.; Yaseen, M.; Kousar, R.; Aamir, A.; Quratulain; Ejaz, R. Constituents and antibacterial activity of leaf essential oil of Plectranthus scutellarioides. Plant Biosyst. 2020, 155, 1247–1252. [Google Scholar] [CrossRef]
- Genovese, C.; D’Angeli, F.; Bellia, F.; Distefano, A.; Spampinato, M.; Attanasio, F.; Nicolosi, D.; Di Salvatore, V.; Tempera, G.; Lo Furno, D.; et al. In vitro antibacterial, anti-adhesive and anti-biofilm activities of Krameria Lappacea (Dombey) burdet & B.B. Simpson root extract against methicillin-resistant Staphylococcus aureus strains. Antibiotics 2021, 10, 428. [Google Scholar] [CrossRef]
- Mbengui, R.; Guessennd, N.; M’boh, G.; Golly, J.; Okou, C.; Nguessan, J.; Dosso, M.; Djaman, J. Phytochemical screening and study of comparative antibacterial activity of aqueous and alcoholic extracts of the leaves and barks of Terminalia catappa on multi resistant strains. J. Appl. Biosci. 2013, 66, 5040–5048. [Google Scholar] [CrossRef]
- Ahmed, Q.; Gupta, N.; Kumar, A.; Nimesh, S. Antibacterial efficacy of silver nanoparticles synthesized employing Terminalia arjuna bark extract. Artif. Cells Nanomed. Biotechnol. 2017, 45, 1192–1200. [Google Scholar] [CrossRef] [PubMed]
- Plazonić, A.; Bucar, F.; Ẑeljan, M.; Mornar, A.; Nigović, B.; Kujundẑić, N. Identification and quantification of flavonoids and phenolic acids in burr parsley (Caucalis platycarpos L.), using high-performance liquid chromatography with diode array detection and electrospray ionization mass spectrometry. Molecules 2009, 14, 2466–2490. [Google Scholar] [CrossRef]
- Lee, D.Y.; Kim, H.W.; Yang, H.; Sung, S.H. Hydrolysable tannins from fruits of Terminalia chebula Retz and their alpha-glucosidase inhibitory activities. Phytochemistry 2017, 137, 109–116. [Google Scholar] [CrossRef]
- Aldawsari, M.F.; Ahmed, M.M.; Fatima, F.; Anwer, M.K.; Katakam, P.; Khan, A. Development and characterization of calcium-alginate beads of apigenin: In vitro antitumor, antibacterial, and antioxidant activities. Mar. Drugs 2021, 19, 467. [Google Scholar] [CrossRef]
- Kubínová, R.; Gazdová, M.; Hanáková, Z.; Jurkaninová, S.; Dall’Acqua, S.; Cvačka, J.; Humpa, O. New diterpenoid glucoside and flavonoids from Plectranthus scutellarioides (L.) R. Br. S. Afr. J. Bot. 2019, 120, 286–290. [Google Scholar] [CrossRef]
- Peng, H.Y.; Zhang, X.H.; Zhong, X.J. Apigenin-7-O-β-d-glycoside isolation from the highly copper-tolerant plant Elsholtzia splendens. J. Zhejiang Univ. Sci. B 2016, 17, 447–454. [Google Scholar] [CrossRef]
- Altamimi, M.A.; Elzayat, E.M.; Alshehri, S.M.; Mohsin, K.; Ibrahim, M.A.; Al Meanazel, O.T.; Shakeel, F.; Alanazi, F.K.; Alsarra, I.A. Utilizing spray drying technique to improve oral bioavailability of apigenin. Adv. Powder Technol. 2018, 29, 1676–1684. [Google Scholar] [CrossRef]
- El-Desouky, S.K.; Ryu, S.Y.; Kim, Y.K. A new cytotoxic acylated apigenin glucoside from Phyllanthus emblica L. Nat. Prod. Res. 2008, 22, 91–95. [Google Scholar] [CrossRef] [PubMed]
- Weber, B.; Herrmann, M.; Hartmann, B.; Joppe, H.; Schmidt, C.O.; Bertram, H.J. HPLC/MS and HPLC/NMR as hyphenated techniques for accelerated characterization of the main constituents in Chamomile (Chamomilla recutita [L.] Rauschert). Eur. Food Res. Technol. 2008, 226, 755–760. [Google Scholar] [CrossRef]
- Witkowska-Banaszczak, E.; Krajka-Kuźniak, V.; Papierska, K. The effect of luteolin 7-glucoside, apigenin 7-glucoside and Succisa pratensis extracts on NF- κB activation and α-amylase activity in HepG2 cells. Acta Biochim. Pol. 2020, 67, 41–47. [Google Scholar] [CrossRef] [PubMed]
- Osonga, F.J.; Akgul, A.; Miller, R.M.; Eshun, G.B.; Yazgan, I.; Akgul, A.; Sadik, O.A. Antimicrobial activity of a new class of phosphorylated and modified flavonoids. ACS Omega 2019, 4, 12865–12871. [Google Scholar] [CrossRef]
- Al-otibi, F.; Al-ahaidib, R.A.; Alharbi, R.I.; Al-otaibi, R.M.; Albasher, G. Antimicrobial Potential of Biosynthesized Silver Nanoparticles. Molecules 2021, 26, 130. [Google Scholar] [CrossRef]
- Aboody, M.S.A.; Mickymaray, S. Anti-Fungal Efficacy and Mechanisms of Flavonoids. Antibiotics 2020, 9, 45. [Google Scholar] [CrossRef]
- Liga, S.; Paul, C.; Peter, F. Flavonoids: Overview of Biosynthesis, Biological Activity, and Current Extraction Techniques. Plants 2023, 12, 2732. [Google Scholar] [CrossRef]
- Wang, M.; Firrman, J.; Liu, L.S.; Yam, K. A review on flavonoid apigenin: Dietary intake, ADME, antimicrobial effects, and interactions with human gut microbiota. BioMed Res. Int. 2019, 2019, 7010467. [Google Scholar] [CrossRef]
- Ivanov, M.; Ćirić, A.; Stojković, D. Emerging Antifungal Targets and Strategies. Int. J. Mol. Sci. 2022, 23, 2756. [Google Scholar] [CrossRef]
- Adamczak, A.; Ożarowski, M.; Karpiński, T.M. Antibacterial activity of some flavonoids and organic acids widely distributed in plants. J. Clin. Med. 2020, 9, 109. [Google Scholar] [CrossRef]
- Zhou, H.; Chen, L.; Ouyang, K.; Zhang, Q.; Wang, W. Antibacterial activity and mechanism of flavonoids from Chimonanthus salicifolius S. Y. Hu. and its transcriptome analysis against Staphylococcus aureus. Front. Microbiol. 2023, 13, 1103476. [Google Scholar] [CrossRef] [PubMed]
- Tagousop, C.N.; Tamokou, J.D.D.; Ekom, S.E.; Ngnokam, D.; Voutquenne-Nazabadioko, L. Antimicrobial activities of flavonoid glycosides from Graptophyllum grandulosum and their mechanism of antibacterial action. BMC Complement. Altern. Med. 2018, 18, 252. [Google Scholar] [CrossRef] [PubMed]
- Echeverr, J.; Opazo, J.; Mendoza, L.; Urz, A.; Wilkens, M. Selected Antibacterial Natural Flavones and Flavanones of Chilean Flora. Molecules 2017, 22, 608. [Google Scholar] [CrossRef]
- Shamsudin, N.F.; Ahmed, Q.U.; Mahmood, S.; Adnan, S.; Shah, A.; Khatib, A.; Mukhtar, S.; Alsharif, M.A.; Parveen, H.; Zakaria, Z.A. Antibacterial Effects of Flavonoids and Their Structure-Activity Relationship Study: A Comparative Interpretation. Molecules 2022, 27, 1149. [Google Scholar] [CrossRef] [PubMed]
- Dias, D.A.; Urban, S.; Roessner, U. A Historical Overview of Natural Products in Drug Discovery. Metabolites 2012, 2, 303–336. [Google Scholar] [CrossRef]
- Solnier, J.; Martin, L.; Bhakta, S.; Bucar, F. Flavonoids as novel efflux pump inhibitors and antimicrobials against both environmental and pathogenic intracellular mycobacterial species. Molecules 2020, 25, 734. [Google Scholar] [CrossRef]
- Morimoto, Y.; Aiba, Y.; Miyanaga, K.; Hishinuma, T.; Cui, L.; Baba, T.; Hiramatsu, K. CID12261165, a flavonoid compound as antibacterial agents against quinolone-resistant Staphylococcus aureus. Sci. Rep. 2023, 13, 1725. [Google Scholar] [CrossRef]
- Jesionek, W.; Móricz, Á.M.; Alberti, Á.; Ott, P.G.; Kocsis, B.; Horváth, G.; Choma, I.M. TLC-direct bioautography as a bioassay guided method for investigation of antibacterial compounds in Hypericum perforatum L. J. AOAC Int. 2015, 98, 1013–1020. [Google Scholar] [CrossRef]
- Qaiyumi, S. Macro and Microdilution methods of antimicrobial susceptibility testing. In Antimicrobial Susceptibility Testing Protocols, 9th ed.; Schwalbe, R., Steele-moore, L., Goodwin, C., Eds.; CRC Press: London, UK; Taylor and Franscis Group: London, UK, 2012; pp. 75–79. [Google Scholar]
- Espinel-Ingroff, S.; Canton, E. Antifungal susceptibility testing for filamentous fungi. In Antimicrobial Susceptibility Testing Protocols, 9th ed.; Schwalbe, R., Steele-moore, L., Goodwin, C., Eds.; CRC Press: London, UK; Taylor and Franscis Group: London, UK, 2012; pp. 209–241. [Google Scholar]

| Test Organism/ Test Compound | S. aureus (MTCC 7443) | S. typhi (MTCC 733) | S. aureus (Clinical Isolate) | P. vulgaris (Clinical Isolate) | MRSA 1503 | MRSA 1007 | M. gypseum | M. canis | T. rubrum |
|---|---|---|---|---|---|---|---|---|---|
| Apigenin 7-O-ß-D-glucopyranoside (µg/mL) | 625 | 625 | 9.5 | 625 | 9.5 | 625 | 312 | 312 | 625 |
| MBC/MFC | 5000 | * | 2500 | 2500 | 2500 | 1250 | 1250 | 1250 | 1250 |
| Effect | Bacteriostatic | Effect not achieved | Bacteriostatic | Bactericidal | Bacteriostatic | Bactericidal | Fungicidal | Fungicidal | Fungicidal |
| Ciprofloxacin (µg/mL) | 0.019 | 0.019 | 0.019 | 0.019 | 0.019 | 0.019 | -- | -- | -- |
| Miconazole (µg/mL) | -- | -- | -- | -- | -- | -- | 0.019 | 0.019 | 0.019 |
Disclaimer/Publisher’s Note: The statements, opinions and data contained in all publications are solely those of the individual author(s) and contributor(s) and not of MDPI and/or the editor(s). MDPI and/or the editor(s) disclaim responsibility for any injury to people or property resulting from any ideas, methods, instructions or products referred to in the content. |
© 2025 by the authors. Licensee MDPI, Basel, Switzerland. This article is an open access article distributed under the terms and conditions of the Creative Commons Attribution (CC BY) license (https://creativecommons.org/licenses/by/4.0/).
Share and Cite
Sowmya, T.N.; Gurudatt, D.M.; Raveesha, K.A. Bioactivity-Guided Isolation of Flavone Glycoside from Terminalia catappa: Evaluating Anti-MRSA and Anti-Dermatophytic Potential. Molecules 2025, 30, 3595. https://doi.org/10.3390/molecules30173595
Sowmya TN, Gurudatt DM, Raveesha KA. Bioactivity-Guided Isolation of Flavone Glycoside from Terminalia catappa: Evaluating Anti-MRSA and Anti-Dermatophytic Potential. Molecules. 2025; 30(17):3595. https://doi.org/10.3390/molecules30173595
Chicago/Turabian StyleSowmya, Tumakuru Nataraj, Doddahosuru Mahadevappa Gurudatt, and Koteshwar Anandrao Raveesha. 2025. "Bioactivity-Guided Isolation of Flavone Glycoside from Terminalia catappa: Evaluating Anti-MRSA and Anti-Dermatophytic Potential" Molecules 30, no. 17: 3595. https://doi.org/10.3390/molecules30173595
APA StyleSowmya, T. N., Gurudatt, D. M., & Raveesha, K. A. (2025). Bioactivity-Guided Isolation of Flavone Glycoside from Terminalia catappa: Evaluating Anti-MRSA and Anti-Dermatophytic Potential. Molecules, 30(17), 3595. https://doi.org/10.3390/molecules30173595

